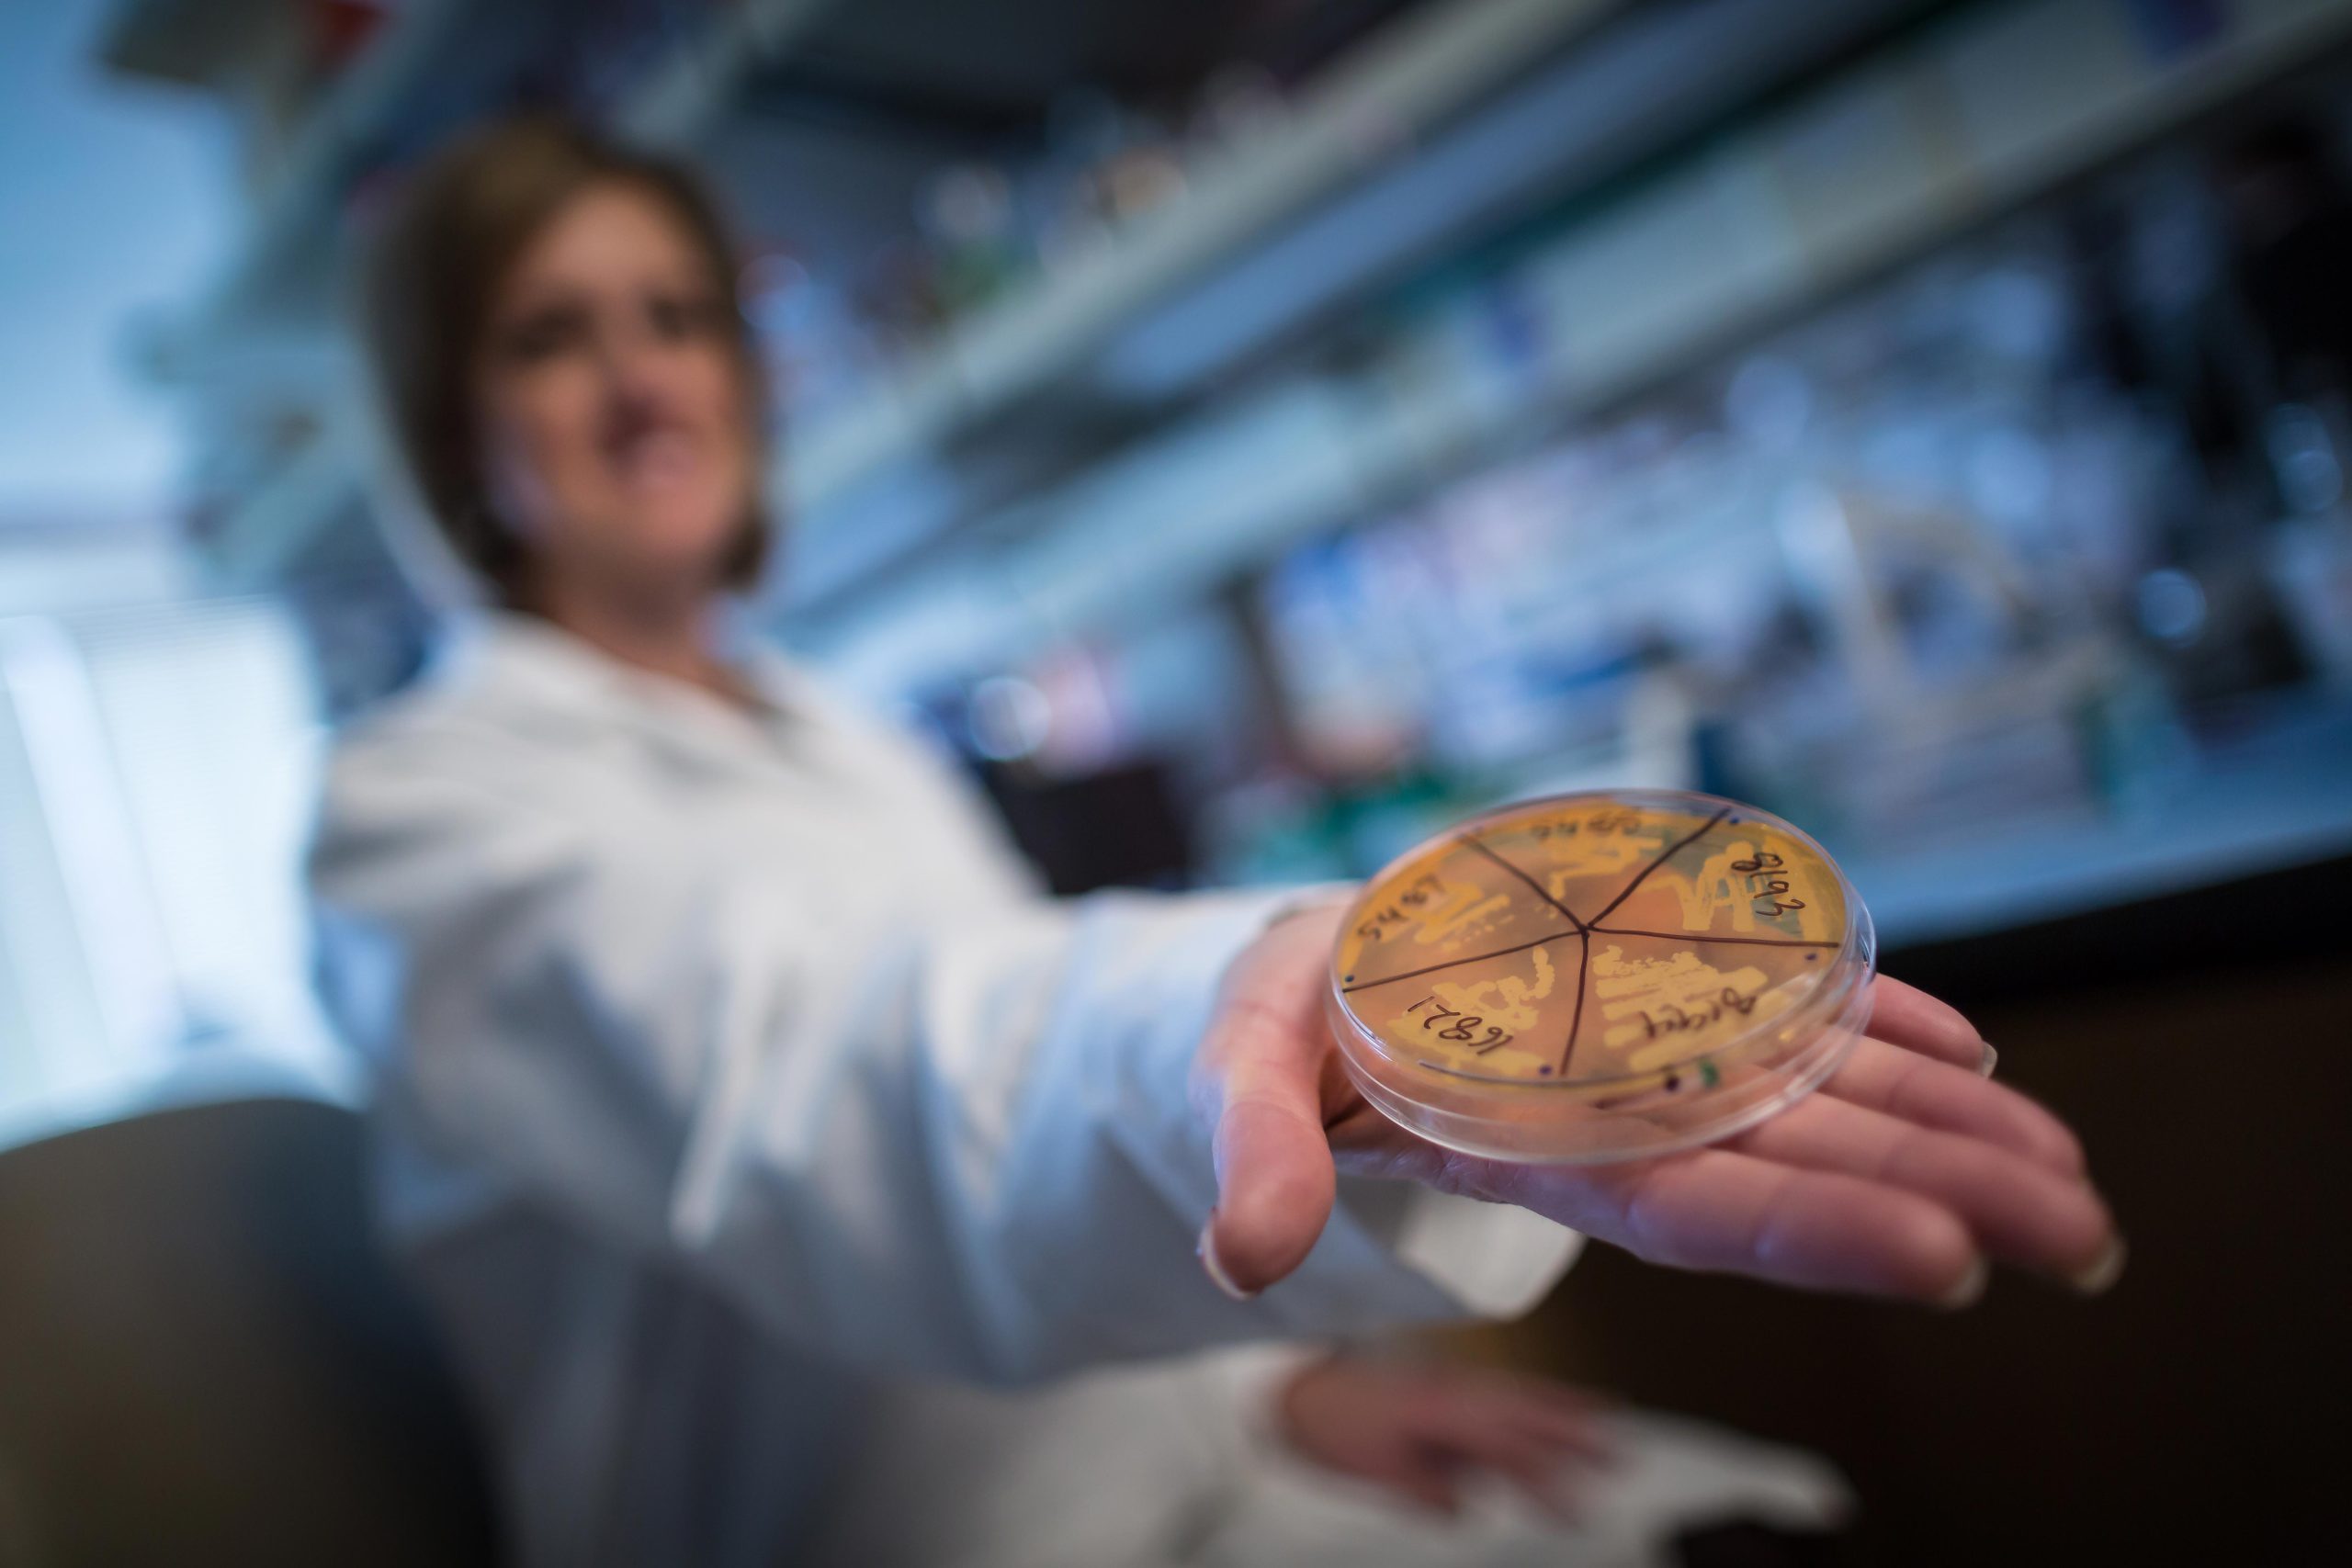
Reducing Diabetes Risk by 85%: Scientists Discover Infant Gut Bugs That Supercharge Insulin Cells - SciTechDaily

health News
Stay updated with the latest health news, articles, and updates.

Trump Sparks Ozempic Mystery With Miraculous Weight Loss - The Daily Beast
The secret of the president’s dramatic weight loss is the talk of the White House, our must-read newsletter The Swamp reveals.

Second case of ‘zombie deer disease’ confirmed in GA - WSB-TV
A second deer in Georgia has tested positive for what is commonly called “zombie deer disease.”
Reducing Diabetes Risk by 85%: Scientists Discover Infant Gut Bugs That Supercharge Insulin Cells - SciTechDaily
Gut microbes in early life play a key role in shaping insulin production and diabetes risk, with Candida dubliniensis showing strong protective effects in mice. New research in mice reveals that the gut microbiome plays a crucial role in the development of in…

Perry Township student hospitalized after fentanyl overdose from THC vape - WTHR
A letter sent to parents of students in the district obtained by 13News said the high school student was using a THC vape that unknowingly contained fentanyl.

It only takes two minutes a day to build up the flexibility required to touch your toes, says a top mobility coach - Fit&Well
Measure, reach and repeat says Roger Frampton

RFK Jr makes wild claim over teenage boys' testosterone and even Jesse Watters is baffled - Irish Star
Kennedy has made a number specious claims since taking office as Secretary of Health and Human Services, including saying autism can somehow be cured and the measles outbreak is "not unusual"

Whooping cough cases surge as vaccine rates fall - The Washington Post
The U.S. has tallied 8,077 cases of whooping cough in 2025, compared with 3,847 cases in the same period last year, federal data shows.

Alzheimer’s disease warning signs found in young adults, study says - The Brighter Side of News
New research reveals Alzheimer’s disease risk factors appear in young adults, decades before symptoms typically emerge.

'One-of-a-kind' girl born with heart outside chest has pioneering surgery - BBC
Vanellope, now seven, undergoes more surgery to reconstruct a "cage" around her heart, using her ribs.
Stroke patients have high levels of microplastics in the plaque clogging their arteries, researchers find - Business Insider
Microplastics discovered in life-threatening arterial plaque are associated with strokes. A new study found altered gene activity, too.
:max_bytes(150000):strip_icc()/Scientists-Just-Discovered-a-Huge-Health-Benefit-of-Pecans-311251b9a2524a738eece7be650ff359.jpg)
Scientists Just Discovered a Heart-Healthy Benefit of Pecans - EatingWell
Learn what this study suggests happens when you replace your typical snack with a small handful of pecans each day, plus ways to enjoy the nuts.

This Daily Habit May Cut Your Cancer Risk by 26% - SciTechDaily
NIH study finds daily step count may matter more than activity intensity for reducing cancer risk. In a prospective cohort study involving over 85,000 adults in the United Kingdom, researchers from the National Institutes of Health (NIH) and the University of…

Eat More of This Type of Food If You Want to Lower Your Blood Pressure - Money Talks News
New research says this is how you could balance your salt intake to keep blood pressure healthy.

New agreement geared toward universal avian flu vaccine - CIDRAP
The mRNA vaccine targets all major clades of the H5 avian flu subtype.

Energy Starvation Triggers Dangerous Glutamate Surges in the Brain - Neuroscience News
A new study shows that when energy is depleted—such as during a stroke—neurons begin releasing glutamate in abnormal, self-amplifying bursts that can damage nerve cells.

Why you should never swim after getting a tattoo as 31-year-old man dies - UNILAD
After a 31-year-old man lost his life after getting a tattoo, a stark reminder has been issued over swimming after getting inked.

Eye Clues to Schizophrenia Risk Found in Retinal Thickness - Neuroscience News
The retina, as part of the central nervous system, may reflect early signs of brain disorders like schizophrenia.

How breast cancer cells become dormant and remain undetected for years, and why they later wake up and metastasize - Medical Xpress
Breast cancer is becoming increasingly treatable, but in some cases the disease can resurface even decades after a patient has been declared cancer free. This is because of cells that detach from the original tumor and hide in a dormant state in the breast or…

How Long Does It Take to Build Muscle? Here’s the Truth - GQ
Protein helps, why fad workouts and diets won’t do it, and more advice from the experts.

Your Brain Learns From Fear, Thanks to Dopamine - Neuroscience News
New research reveals how dopamine helps the brain learn to avoid unpleasant outcomes by responding differently in distinct brain regions during negative experiences.